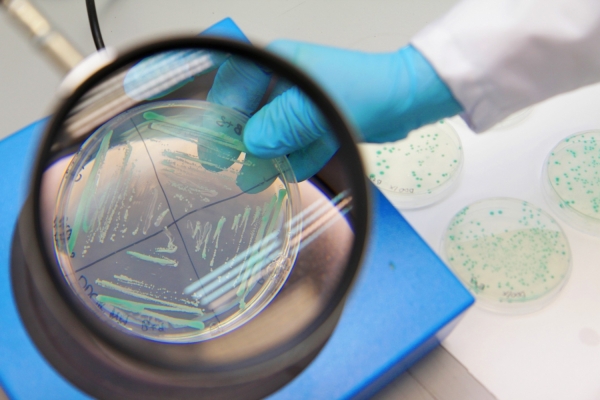

Informacje o kierunku studiów
Kierunek: biotechnologia (s2)
Czym jest biotechnologia?
Biotechnologia jest jedną z najdynamiczniej rozwijających się dyscyplin naukowych. Jej celem jest opracowywanie nowych procesów technologicznych w oparciu o osiągnięcia nauk biologicznych. Kształcenie w zakresie biotechnologii jest odpowiedzią na zapotrzebowanie licznych gałęzi gospodarki, które w szerokim zakresie wykorzystują praktyczne rozwiązania dostarczane przez biotechnologów. Ponadto biotechnologia może dostarczyć narzędzi pomocnych w rozwiązaniu palących problemów współczesności, takich jak zagrożenia związane z globalnymi zmianami klimatycznymi, zanieczyszczeniem środowiska naturalnego czy zapewnieniem bezpieczeństwa żywnościowego. Biotechnologia ma kluczowe znaczenie dla konkurencyjności gospodarki, dlatego wskazane jest wykorzystanie potencjału naukowego tej dziedziny w celu tworzenia nowych produktów i technologii.
Dlaczego warto studiować biotechnologię na UMK?

Studiując biotechnologię na UMK:
- uzyskasz tytuł magistra w ramach studiów II stopnia;
- uzyskasz wiedzę umożliwiającą projektowanie procesów biotechnologicznych;
- uzyskasz przygotowanie praktyczne, umożliwiające stosowanie zaawansowanych technik badania organizacji i ekspresji materiału genetycznego, wykrywania, identyfikowania i modyfikowania białek, tworzenia konstruktów genetycznych, modyfikowania genetycznego roślin i zwierząt, wykrywania GMO w materiale biologicznym i żywności zwierząt, wykorzystania mikroorganizmów w różnych gałęziach przemysłu, metod bioobrazowania i badania ultrastruktury komórek, biotechnologii enzymów;
- w ramach realizacji projektu magisterskiego możesz zrealizować indywidualny projekt badawczy;
- skorzystasz z laboratoriów wyposażonych w nowoczesną aparaturę badawczą, multimedialnych sal wykładowych, pracowni komputerowych oraz zbiorów bibliotecznych, wsparcia wykwalifikowanej kadry dydaktycznej;
- skorzystasz z szerokiej oferty stypendiów naukowych i socjalnych oraz możliwości wynikających z doskonałej organizacji miasteczka akademickiego;
- będziesz miał możliwość poszerzania swojej wiedzy, umiejętności i kompetencji poprzez studia na innych uczelniach w Polsce (w ramach programu MOST) oraz na uniwersytetach europejskich (w ramach programu ERASMUS+).
Co po studiach?

Sylwetkę absolwenta kierunku biotechnologia określają wiedza, umiejętności i kompetencje, zatem jest on cenionym reprezentantem nowoczesnej dziedziny wiedzy.
Absolwenci znajdują zatrudnienie m.in.:
- jako specjaliści lub eksperci w instytutach oraz ośrodkach badawczych opracowujących i wdrażających nowoczesne techniki i technologie, zwłaszcza w przemyśle farmaceutycznym, kosmetycznym, chemicznym, spożywczym oraz w rolnictwie;
- w laboratoriach badawczo-rozwojowych, kontrolnych i diagnostycznych;
- w instytucjach zajmujących się nadzorem i kontrolą jakości środowiska (oczyszczalnie ścieków, kompostownie odpadów);
- we własnych firmach, gdyż uzyskane umiejętności i kompetencje pozwalają na założenie i prowadzenie takiej działalności;
- w nauce (uczelnie, instytuty badawcze).